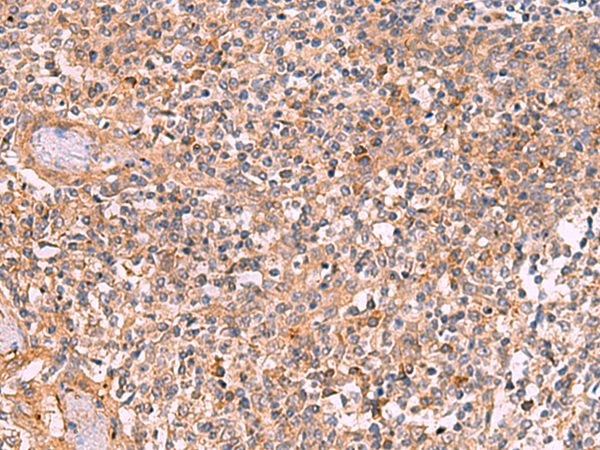

-
分类: 科研抗体货号: P13677别名: HBO1; HBOA; MYST2; ZC2HC7应用: IHC反应种属: Human, Mouse, Rat
-
分类: 科研抗体货号: P13654别名: MIBP; NRK2; ITGB1BP3应用: IHC反应种属: Human
-
分类: 科研抗体货号: P13675别名: CBP; RSTS; KAT3A; RSTS1应用: IHC反应种属: Human, Mouse, Rat
-
分类: 科研抗体货号: P13652别名:应用: WB,IHC反应种属: Human, Mouse, Rat
-
分类: 科研抗体货号: P13670别名: ANKRD47应用: IHC反应种属: Human, Mouse
-
分类: 科研抗体货号: P13649别名:应用: WB反应种属: Human, Mouse, Rat
-
分类: 科研抗体货号: P13648别名: IRX7; IRX-3; IRXB3应用: IHC反应种属: Human
-
分类: 科研抗体货号: P13669别名: KLKL3; KLK-L3应用: IHC反应种属: Human
-
分类: 科研抗体货号: P13668别名: ZNF348; ZNF-kaiso应用: IHC反应种属: Human
-
分类: 科研抗体货号: P13646别名: IRXA3应用: WB,IHC反应种属: Human, Mouse

鄂公网安备42018502007531号
鄂公网安备42018502007531号

